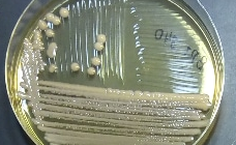
Pesquisa

Grupo de pesquisa descreve nova espécie de levedura da Mata Atlântica alagoana
O artigo científico foi publicado no jornal da Microbiology Society
- Atualizado em

Mesmo em tempo de pandemia do covid-19 e distanciamento social, a produção científica da Universidade Federal de Alagoas (Ufal) continua apresentando ótimos resultados. Recentemente, o grupo de pesquisa do Laboratório de Diversidade Molecular do Instituto de Ciências Biológicas e da Saúde (ICBS), publicou artigo na renomada revista científica da Microbiology Society.
O grupo de pesquisa é coordenado pela professora Melissa Fontes Landell e desenvolve pesquisas na área de diversidade, taxonomia e biotecnologia de micro-organismos. “Estes trabalhos vão desde o uso de técnicas clássicas até técnicas moleculares, como por exemplo, metagenômica. Estudamos micro-organismos de diferentes biomas: Mata Atlântica, caatinga e marinho costeiro”, relatou a professora.
A pesquisa que deu origem ao artigo publicado para a descrição da espécie nova de levedura Vishniacozyma alagoana iniciou com o trabalho de Programa Institucional de Bolsas de Iniciação Científica (Pibic), do aluno Ciro Ramón Félix sobre diversidade de leveduras associadas a bromélias da Mata Atlântica. “Atualmente, Ciro está cursando doutorado em Diversidade Biológica e Conservação nos Trópicos, e agora estudando leveduras da Caatinga”, informa a professora.
O trabalho teve a participação de mais dois alunos do Pibic e um aluno de mestrado pelo Programa de Estudantes-Convênio de Pós-Graduação (PEC-PG), Hector Mauricio Navarro. A professora Melissa Landell destacou ainda que o trabalho contou com a colaboração de um dos maiores taxonomistas de leveduras, Jack Fell, professor da University of Miami. O artigo foi publicado em uma das revistas mais importantes para a área de taxonomia de micro-organismos, a International Journal of Systematic and Evolutionary Microbiology.
A professora do ICBS destacou a relevância da publicação para o grupo de pesquisa da Ufal. “Para nós, isso é um prêmio por todo o trabalho que vem sendo desenvolvido pelo nosso grupo de pesquisa. Nomeamos a espécie como V. alagoana como forma de homenagear o estado de onde boa parte dos isolados de leveduras foram obtidos. Estas leveduras foram isoladas da Mata Atlântica e da Caatinga alagoana e todo trabalho foi desenvolvido no laboratório da Ufal”, ressalta Melissa.
A professora destaca que trabalhos como esse sobre a descrição de uma nova espécie são extremamente importantes para ciência, além de contribuir para conservação e preservação ambiental e ser também um fonte de recursos biotecnológicos. “Publicar este artigo durante esse período tão difícil que estamos passando só ressalta a importância da ciência e que devemos, apesar das dificuldades impostas pela quarentena, manter o foco”, comemora Melissa Landell.
Os estudantes envolvidos no projeto também comemoraram bastante a conquista. “Recebi a notícia da publicação com muita alegria. Esses momentos são a ‘cereja do bolo´’ no processo científico e geram um sentimento de dever cumprido. A publicação de uma nova espécie em especial tem uma carga histórica importante por remeter aos grandes naturalistas e expandir o nosso conhecimento da biodiversidade dando identidade a espécie", declarou Ciro Ramón Félix.
Hector Mauricio Navarro, que é da Colômbia, destacou como conseguir publicar um artigo em uma revista científica renomada pode enriquecer o currículo. “É um grande estímulo para continuar na vida acadêmica e procurar melhorias na formação em nível de doutorado, que está sendo desenvolvido também sob a orientação da professora Melissa”, destaca o estudante.
Para uma estudante que ainda está na graduação, como Dayse Andrade, a conquista é ainda mais estimulante. “A publicação do artigo, em meio a pandemia me trouxe novo ânimo, reafirmando a seriedade da pesquisa desenvolvida e a importância da divulgação do conhecimento científico. Ter a oportunidade e confiança de colaborar com a publicação do artigo ainda cursando a graduação foi maravilhoso, despertando ainda mais a vontade de ingressar na pós-graduação e demonstrando o devido respaldo da bolsa de iniciação científica que recebi durante a pesquisa realizada no laboratório”, comemorou Dayse.
James Henrique, também é estudante da graduação em Biologia e ressaltou que a publicação de artigo nesta etapa inicial da vida acadêmica não é muito frequente. “Ainda mais em uma revista renomada, e que traz bastante prestígio tanto para o grupo de pesquisa quanto para o meu currículo acadêmico. É muito importante na atual situação da sociedade ressaltar a importância da ciência, bem como suas contribuições para a sociedade”, finalizou o estudante.